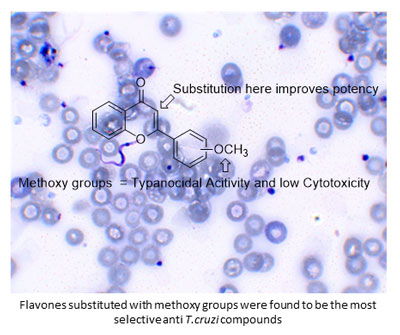

vol. 13, No. 1, 2021, p. 1-307
Procedimentos de Submissão para Open Access
Os manuscritos submetidos na Revista Virtual de Química (RVq) adotam a implementação total do sistema open access, onde os autores contribuem com parte dos custos da Publicação de seus artigos. Ver mais...
Determinação Direta de Cromo em Melado de Cana por GF AAS
Fernanda Galvão  , Maria Lurdes Felsner
, Maria Lurdes Felsner

http://dx.doi.org/10.21577/1984-6835.20200127
Ocorrência, Biossíntese, Síntese e Aplicações de S-Glicosídeos: uma Visão Geral
Romário Jonas de Oliveira; Bruna Martins Guimarães; Rayane de Oliveira Silva; Luiz Eduardo Gomes de Holanda; Clécio Souza Ramos; Juliano Carlo Rufino Freitas  ; João Rufino de Freitas Filho
; João Rufino de Freitas Filho

http://dx.doi.org/10.21577/1984-6835.20200130
Desenvolvimento de um Biossensor Eletroquímico Baseado em HRP-MWCNT para Determinação de Compostos Fenólicos em Efluentes da Lavagem de Grãos de Café
Raquel Reis Duarte, Juliana de Fátima Giarola, Daniela Nunes da Silva, Adelir Aparecida Saczk, César Ricardo Teixeira Tarley, Emerson Schwingel Ribeiro, Arnaldo César Pereira

http://dx.doi.org/10.21577/1984-6835.20200129
PDF Informação suplementar (Vídeo) Informação suplementar Compartilhar
Total access: 1942
Metodologias Acessíveis para a Quantificação de Flavonoides e Fenóis Totais em Própolis
Maria Cristina Marcucci, Antônio Salatino, Laís Farias Azevedo de Magalhães Oliveira, Carolina Passarelli Gonçalves

http://dx.doi.org/10.21577/1984-6835.20200131
Butirilcolinesterase - BuChE: um Potencial Alvo para o Desenvolvimento de Fármacos para o Tratamento da Doença de Alzheimer
Paula do N. Goulart, Lucas Caruso, Nathália F. Nadur, Daiana P. Franco, Arthur E. Kümmerle  , Renata B. Lacerda
, Renata B. Lacerda

http://dx.doi.org/10.21577/1984-6835.20200133
Classificação do Teor de Biodiesel Metílico de Macaúba na Mistura com Diesel, por Meio da Combinação das Técnicas Analíticas/ Quimiométricas de Espectroscopia MIR e PLS-DA
Lígia R. de Oliveira  , Ademar D. V. Máquina, Baltazar V. Sitoe, Lucas G. da Costa, Raiana R. Seixas, Douglas Q. Santos
, Ademar D. V. Máquina, Baltazar V. Sitoe, Lucas G. da Costa, Raiana R. Seixas, Douglas Q. Santos

http://dx.doi.org/10.21577/1984-6835.20200134
Atividade Inibitória e Estudos de Docking da Catepsina V para Isoflavanoides de Dalbergia Miscolobium Benth
Eder L. e Silva, Laysa L. P. F. Moreira, Weverson C. Cardoso, Rodrigo R. Kitagawa, Keyller B. Borges, Paulo C. Vieira, Pedro A. B. Morais, Warley de S. Borges

http://dx.doi.org/10.21577/1984-6835.20200135
Avaliação In Vitro de Flavonas Sintéticas contra o Trypanosoma cruzi
Josimara Souza Andrade, Leonardo Gomes de Abreu, Policarpo Ademar Sales Junior, Silvane Maria Fonseca Murta, Jason Guy Taylor
http://dx.doi.org/10.21577/1984-6835.20200136
Nitrato de Amônio: Mocinho ou Vilão?
Sidney Silva Simplicio, Victória L. dos Anjos Santos  , Wesley R. Alcantara Campos, Délis Galvão Guimarães, Arlan de Assis Gonsalves
, Wesley R. Alcantara Campos, Délis Galvão Guimarães, Arlan de Assis Gonsalves  , Cleônia Roberta M. Araújo
, Cleônia Roberta M. Araújo

http://dx.doi.org/10.21577/1984-6835.20200139
Aspectos Fisiopatológicos da Inflamação e o Planejamento de Fármacos: uma Visão Geral Atualizada
Rachelle Etienne, Flávia Pereira Dias Viegas, Claudio Viegas Jr.

http://dx.doi.org/10.21577/1984-6835.20200138
Determinação do Teor de Ferro Utilizando o Aplicativo PhotoMetrix PRO®: a Tecnologia a favor do Ensino de Química
Emilene de C. Lourenço, Salete de Paula, Grazielle de O. Setti, Aline T. Toci  , Janine C. Padilha
, Janine C. Padilha  , Eleandro M. da Silva, Marcela Boroski
, Eleandro M. da Silva, Marcela Boroski

http://dx.doi.org/10.21577/1984-6835.20200137
Atividade Biológica da Purpurogalina e seus Derivados
Iasmim L. Silva  , Celso A. Camara
, Celso A. Camara

http://dx.doi.org/10.21577/1984-6835.20200141
Estudo Físico-Químico e Quimiométrico de Méis do Estado do Pará
José Marcos Nobre de Mora Junior, Charles Alberto Brito Negrão, Ronaldo Magno Rocha, Ewerton Carvalho de Souza, Antonio dos Santos Silva

http://dx.doi.org/10.21577/1984-6835.20200142
Uma Abordagem Química Inovativa e Acessível Para a Identificação de Bisfenol em Superfícies Plásticas
João P. de J. Pereira  , Caroline de S. Moura, Cláudia Ayres, Leila M. Stávale
, Caroline de S. Moura, Cláudia Ayres, Leila M. Stávale

http://dx.doi.org/10.21577/1984-6835.20200146
Comparação entre a Hidrólise Química e Enzimática da Biomassa Lignocelulósica para a Produção de Bioetanol: uma Revisão
Bruna Ezequielle Bernardes Costa, Rosenira Serpa da Cruz, Fernando Cesário Rangel, Simoni Margareti Plentz Meneghetti 

http://dx.doi.org/10.21577/1984-6835.20200140
Perfil Químico Biomonitorado das Folhas de Piper marginatum durante a Ontogenia
Giselle Barbosa Bezerra, Clécio Souza Ramos

http://dx.doi.org/10.21577/1984-6835.20200143
Terapia de Captura de Nêutrons pelo Boro: uma Nova Visão sobre o Tratamento do Câncer
Danielle Dias Neves, Mônica Freire Belian  , Wagner Eduardo da Silva, Eudice Correia Vilela
, Wagner Eduardo da Silva, Eudice Correia Vilela

http://dx.doi.org/10.21577/1984-6835.20200147
Caracterização Físico-Química de Geleia e Doce Elaborados com Polpa de Maracujá Saborizados com Flor de Camomila (Matricaria chamomilla)
Priscilla A. Silva, Luana da S. Pinheiro, Rodrigo C. Silva, João Paixão dos S. Neto, Fábio Israel. M. Carvalho

http://dx.doi.org/10.21577/1984-6835.20200145
Editoria da RVq - Editoria da RVq - PubliSBQ
Instituto de Química, Universidade Federal Fluminense,
Campus do Valonguinho, 24020-141, Centro, Niterói-RJ, Brasil
E-mail: rvq@sbq.org.br


